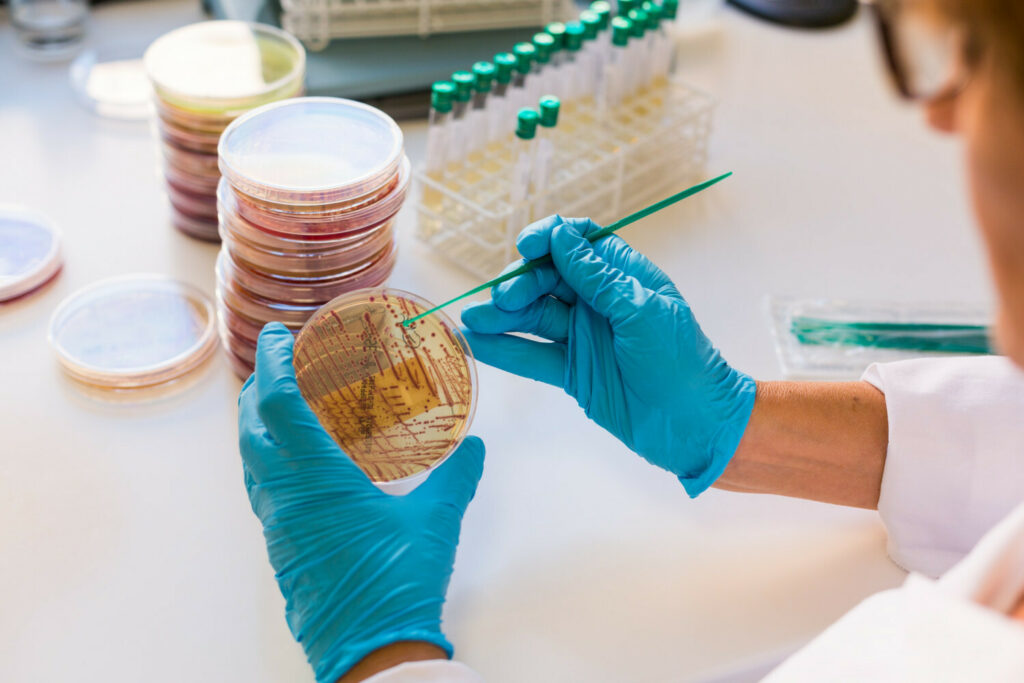

Naukowcy z Wydziału Geoinżynierii Uniwersytetu Warmińsko-Mazurskiego (UWM) w Olsztynie badają rosnący poziom oporności na antybiotyki i potencjalny wpływ na to zjawisko niedostatecznej dezynfekcji szpitalnych ścieków.
W szpitalach nawet jedna trzecia pacjentów codziennie otrzymuje antybiotyki, a więc ścieki szpitalne uważane są za jedną z głównych dróg rozprzestrzeniania się genów oporności na antybiotyki.
Badania prowadzone w Katedrze Inżynierii Ochrony Wód i Mikrobiologii Środowiskowej UWM wpisują się w najnowsze europejskie plany działań na rzecz zwalczania oporności na środki przeciwdrobnoustrojowe – mówi Damian Rolbiecki, kierownik projektu.
Na potrzeby projektu naukowcy pobrali już próbki (w różnych warunkach, w każdej z czterech pór roku), a teraz przystępują do badań molekularnych, które pozwolą na analizę materiału genetycznego obecnego w ściekach szpitalnych, czyli poznania różnych gatunków bakteryjnych obecnych w nich, ich oporności na dezynfekaty oraz antybiotyki i przypisanie odpowiednich systemów oporności określonym gatunkom bakterii.
jp









